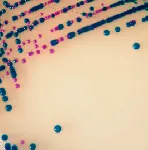

CHROMagar™ Strep B
Chromogenic dehydrated medium for the isolation and differentiation of Streptococcus agalactiae (GBS).

Chromogenic dehydrated medium for the isolation and differentiation of Streptococcus agalactiae (GBS).

Features
Presentation
Dehydrated medium to prepare 25 liters Type of packaging
bulk
Dehydrated medium to prepare 25 liters Type of packaging
bulk

 Rest of the World
Rest of the World